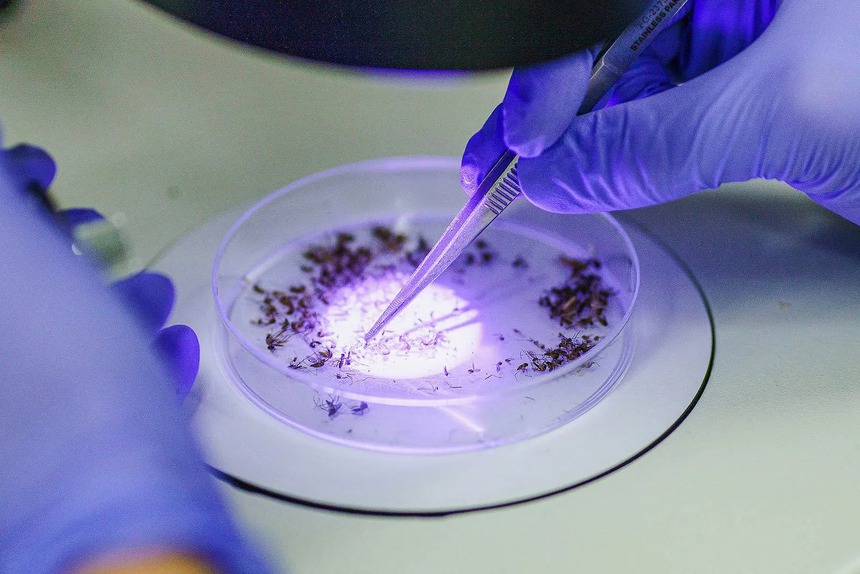
Phương pháp diệt muỗi bằng muỗi đang cho thấy hiệu quả cao - Ảnh 1. Phương pháp diệt muỗi bằng muỗi đang cho thấy hiệu quả cao - Ảnh 1.

Muỗi Aedes aegypti là loài côn trùng không chỉ gây phiền toái mà còn là loài trung gian mang các mầm bệnh nguy hiểm như sốt xuất huyết, sốt vàng da, chikungunya và virus Zika. Dễ dàng nhận ra chúng với các các sọc đen và trắng trên chân, đây là một trong những loài côn trùng nguy hiểm nhất đối với con người.
Tại thành phố Indaiatuba của Brazil, một nỗ lực đang được tiến hành để loại bỏ những loài gây hại này trước khi chúng có cơ hội truyền bệnh. Và vũ khí của các nhà khoa học lại là nhiều muỗi Aedes aegypti hơn. Nhưng đây là những con muỗi đã được biến đổi gen được trao trọng trách tiêu diệt đồng loại của chúng. Được sản xuất bởi công ty công nghệ sinh học Oxitec của Anh, thực tế cho thấy những con muỗi này đang mang lại hiệu quả tốt.
Về cơ bản, những con muỗi biến đổi này mang gen tự giới hạn tổng hợp, có tác dụng ngăn cản con cái sống sót. Điều này rất quan trọng, vì chỉ có con muỗi cái mới đốt và truyền bệnh. Trong một nghiên cứu mới, các nhà khoa học tại công ty Oxitec đã chỉ ra rằng những con côn trùng được biến đổi gen của họ có thể giúp giảm tới 96% số lượng muỗi Aedes aegypti tại địa phương trong vòng 11 tháng, ở những khu vực lân cận nơi chúng được thả.
Nathan Rose, người đứng đầu các chương trình sốt rét tại Oxitec cho biết: “Đây là khu vực có mật độ muỗi Aedes aegypti cao và chúng thường xuyên bùng phát dịch sốt xuất huyết”.
Những con muỗi biến đổi gen được tạo ra trong phòng thí nghiệm.
Vào mùa hè năm nay, Bộ Y tế Brazil đã báo cáo rằng bệnh sốt xuất huyết đang tiếp tục lan rộng ở cả 5 khu vực của đất nước. Từ ngày 1/1 đến ngày 31/5, Brazil có hơn 1,1 triệu ca mắc bệnh, tăng 198% so với cùng kỳ năm 2021. Trong 5 tháng đó, căn bệnh gây sốt cao, phát ban, đau cơ và khớp này đã giết chết 504 người.
Đối với nghiên cứu được thực hiện vào năm 2018 và 2019, công ty Anh đã chọn bốn khu dân cư đông đúc có mức độ muỗi Aedes aegypti cao. Các nhà khoa học đã thả 100 con muỗi đực làm hai lần cho mỗi khu cư dân mỗi tuần. Ở những nơi khác, họ đã điều chỉnh con số đó lên tới 500 con.
Những con đực biến đổi gen đã giao phối với những con muỗi cái hoang dã, nhưng hệ gen được chỉnh sửa đã ngăn không cho con cái sống sót. Gen này được thiết kế trong phòng thí nghiệm, dựa trên các nguyên tố có trong vi rút E. coli và herpes simplex, khiến các tế bào của con muỗi cái sản xuất ra nhiều protein gọi là tTAV. Điều này cản trở khả năng tạo ra các protein thiết yếu khác cần thiết cho sự phát triển của tế bào. Kết quả là, những con cái chết trước khi trưởng thành và bắt đầu đốt người. Các con muỗi đực con trong khi đó vẫn sống sót, mang theo một bản sao của gen tự giới hạn để tiếp tục truyền cho đời sau.
Để xác định mức độ hiệu quả của những con muỗi đực biến đổi gen này, các nhà khoa học phải đánh giá quần thể muỗi tại địa phương trước và sau thí nghiệm. Họ sử dụng cách dẫn dụ, bẫy và kiểm đếm số lượng muỗi trưởng thành trong một khu vực, hoặc đặt bẫy chứa đầy nước, sau đó đếm số trứng muỗi cái đẻ trong đó. Sau đó, họ dùng các phép tính ngoại suy để có được ước tính số muỗi trong khu vực.
Nghiên cứu này cho thấy rằng trong mùa muỗi cao điểm, kéo dài từ tháng 11 đến tháng 4 ở Brazil, quần thể muỗi được xử lý đã bị tiêu diệt trung bình 88% và trong một số trường hợp lên đến 96%, so với những quần thể ở khu vực lân cận.

Các nghiên cứu mới về việc tiêu diệt muỗi đang cho thấy sự hiệu quả hơn phun thuốc.
“Thật thú vị, liều lượng của muỗi đực được thả dường như không tạo ra sự khác biệt về mức độ hiệu quả của phương pháp này”, Rose nói: “Có một số lượng hạn chế muỗi cái tồn tại trong môi trường và điều quan trọng là bạn phải tối đa hóa cơ hội để chúng gặp một trong những con muỗi đực được thả ra này”.
“Chúng tôi nghĩ rằng miễn là có nhiều muỗi đực loại này trong môi trường hơn so với những con đực hoang dã, thì khả năng cao là con cái sẽ tìm thấy một trong những con muỗi của Oxitec”, chuyên gia này chia sẻ thêm. Trên thực tế, Rose nghĩ rằng có thể thả ít muỗi hơn mà vẫn đạt được hiệu quả tương tự.
Giống như các quốc gia khác, Brazil đã tiến hành phun thuốc diệt côn trùng quy mô lớn để kiểm soát các loài muỗi gây hại. Aedes aegypti đã từng bị diệt trừ ở phần lớn Nam Mỹ sau khi sử dụng rộng rãi loại thuốc chứa độc tố DDT vào những năm 1950. Nhưng sau khi tác hại của hóa chất đối với sức khỏe và môi trường được đưa ra ánh sáng, việc phun loại thuốc này đã bị dừng lại và muỗi nhanh chóng bùng phát trở lại. Ngày nay, hợp chất chứa pyrethroid thường được sử dụng để kiểm soát muỗi, nhưng các con muỗi ngày càng cho thấy chúng có khả năng chống lại các hóa chất quen thuộc.
Raul Medina, một nhà côn trùng học tại Đại học Texas A&M, cho rằng thuốc diệt côn trùng khó có thể kiểm soát dịch bệnh vì chúng ảnh hưởng đến các loài côn trùng khác ngoài muỗi và muỗi cũng có thể bay đến các khu vực bên ngoài địa điểm phun thuốc. Tiếp xúc nhiều với thuốc diệt côn trùng đã được chứng minh là gây đau đầu, cay mắt, chóng mặt, tiêu chảy và các vấn đề về hô hấp. Đối với ông, muỗi biến đổi gen đại diện cho một lựa chọn mới theo kiểu “nhắm mục tiêu” mà không có rủi ro về sức khỏe hoặc môi trường.
Oxitec đã tiến hành các thử nghiệm thực địa trước đây để cho thấy công nghệ của họ có thể làm giảm quần thể muỗi địa phương, nhưng đây là nghiên cứu được công bố đầu tiên sử dụng việc đưa trứng ra ngoài môi trường thay vì các con muỗi đực trưởng thành. Các phiên bản muỗi biến đổi gen trước đó thường yêu cầu các nhà khoa học ấp các loài côn trùng trong phòng thí nghiệm, phân loại chúng theo giới tính và thả những con đực vào khu vực thử nghiệm. Giờ đây, trứng được đựng trong hộp, rẻ hơn và ít tốn công hơn. Trong vòng vài ngày sau khi các nhà khoa học thêm nước vào hộp, những con muỗi đực nở ra và tìm kiếm bạn tình.
Medina cho biết chiến lược dùng hộp có thể mang lại lợi ích cho các nước nghèo hơn vì nó cần ít lao động hơn để triển khai. Nhưng tần suất các hộp cần được bổ sung để hạn chế số lượng muỗi đực tại địa phương có thể là một trở ngại cho việc áp dụng chúng.
Muỗi đực có tuổi thọ ngắn - chỉ từ 7 đến 10 ngày - và đặc điểm gen tự giới hạn cũng trở nên ít phổ biến hơn ở mỗi thế hệ muỗi đực tiếp theo. Do đó, hiệu quả sẽ giảm dần theo thời gian. Đồng nghĩ với việc các nhà khoa học vẫn phải cập nhật phiên bản chỉnh sửa gen của họ.
Tuy nhiên, vẫn còn một câu hỏi lớn chưa được trả lời. Đó là liệu việc thả những con muỗi này có thực sự làm giảm sự lây truyền bệnh hay không. Bởi giảm lượng muỗi không đồng nghĩa với giảm sự lây truyền bệnh.
Bởi ngay cả việc diệt trừ muỗi ở một khu vực nhất định cũng không nhất thiết diệt trừ được những căn bệnh mà chúng lây lan, bởi vì muỗi luôn có thể di cư. Nhà côn trùng học Medina nói: “Mỗi khi bạn gặp một vấn đề phức tạp, bạn cần mong đợi một câu trả lời phức tạp và việc kiểm soát muỗi là một ví dụ hoàn hảo cho điều đó.”
Tham khảo Wired